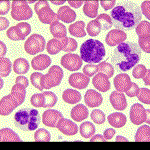
Células sanguíneas; en el centro de la imagen se aprecia un linfocito.

|
|
ASPECTOS PREVENTIVOS: DIAGNÓSTICO PRENATAL

Mediante el diagnóstico prenatal es posible
saber si se está gestando un niño cromosómicamente normal.
El diagnóstico prenatal permite a los padres prevenir enfermedades
congénitas o malformaciones serias y mejorar el futuro de los bebés
con problemas.
El diagnóstico prenatal está indicado:
1. En mujeres cuya edad es superior a los 35 años.
2. Cuando se tienen antecedentes de hijos o familiares con alguna anomalía cromosómica.
3. En personas sanas pero portadoras de alguna anomalía cromosómica.
4. Cuando se detecta alguna anomalía durante el embarazo, como variaciones
en el volumen del
líquido amniótico, o alteraciones en el crecimiento o desarrollo del bebé.
5. En parejas con antecedentes de abortos recurrentes y embarazo en curso.
6. En personas con historia familiar de trastornos metabólicos congénitos
Estudios genéticos
Se realiza un examen cromosómico con distintas técnicas,
habitualmente a partir de linfocitos sanguíneos, para obtener
información sobre la enfermedad, su evolución y pronóstico,
el posible tratamiento, el modo de transmisión hereditario,
el riesgo de repetición y si existe diagnóstico prenatal
posible para esa enfermedad.

Los defectos congénitos más frecuentes son:
1. Alteraciones cromosómicas: En teoría se pueden diagnosticar todas; su incidencia es del cinco por
mil de los recién nacidos. Son la causa principal que aconseja realizar una amniocentesis.
2. Defectos del tubo neural: Su frecuencia es de uno por cada 1000 nacimientos; se puede detectar
estudiando una proteína del liquido amniótico, la alfa cetoproteína.
3. Trastornos hereditarios del metabolismo.
Otras enfermedades tales como
las espina bífida, el encefalocele o la anencefalia, también pueden
diagnosticarse por el estudio del líquido amniótico al mismo tiempo
que se realiza el estudio cromosómico.
Procedimientos utilizados en el Diagnóstico Prenatal :
Existen varios métodos de diagnóstico y
control. Puede conocerse la constitución genética del feto a través del
análisis cromosómico y de la detección de genes anormales para un número
creciente de enfermedades. Los estudios genéticos del feto se
realizan actualmente en el primer trimestre del embarazo mediante
la biopsia coriónica (o placentaria) y, en el segundo trimestre de
la gestación, a través del estudio del líquido amniótico.
1. Biopsia de vellosidades coriónicas:
Consiste en la extracción y estudio de células de las vellosidades
coriónicas, donde entran en contacto los tejidos de la madre con los del
feto. Se efectúa entre la semana 11ª y 12ª del embarazo. Tiene un riesgo
de aborto del 1%, y tiene la ventaja de que los resultados se obtienen en
menos de una semana.
2. Amniocentesis:
Se hace una punción hasta la cavidad uterina a través de la pared abdominal
en la semana 6ª de gestación, para obtener liquido amniótico. Tiene un
riesgo de aborto inferior al 0,5%, pero tiene el inconveniente de que
los resultados no se obtienen hasta pasadas tres o cuatro semanas de
haber hecho la punción.

Cada embarazada tiene un
riesgo cercano al 3 % de tener un hijo con alteraciones que no
pueden ser detectadas por la amniocentesis, como pueden ser
malformaciones cardiacas, labio leporino o retraso mental.
Para estas enfermedades no hay estudios prenatales exactos.
Riesgos de la Amniocentesis
* Aborto
* Pérdida de líquido, sangrado, calambres
* Problemas si es Rh Negativo: Si la mujer embarazada tiene
sangre con factor Rh negativo y el padre del bebé es Rh positivo,
a esta paciente debería serle aplicada una inyección de
Inmunoglobulina Rh después de la amniocentesis para prevenir
la sensibilización del bebe.
* Infecciones
3. Técnicas de citogenética:
El objetivo es obtener células que se están dividiendo.
Se consigue a partir de una muestra de sangre, en la que se
estimula la división de los linfocitos. Al tercer día se detiene
esta división en una fase en la que los cromosomas están
individualizados y separados unos de otros: la metafase.
Luego se rompe la célula para que queden libres los
cromosomas que serán observados al microscopio.
Finalmente se aplica la técnica
de bandeo que pone de manifiesto una serie de bandas a lo largo de cada
cromosoma que se repiten de forma constante, lo que se llama patrón de bandas.
Esto sirve para diagnosticar cuándo falta o sobra una porción de un cromosoma.
Estudios cromosómicos en material de aborto espontáneo
El estudio cromosómico del material de
aborto espontáneo permite en algunos casos poner en evidencia
alteraciones que pueden ser heredadas y aportan información
para futuros embarazos. En la especie humana del 15% al 25% de
los embarazos reconocidos clínicamente terminan en abortos
espontáneos, y al menos el 60% de los abortos del primer
trimestre son cromosómicamente anormales. Cuanto más temprano
es el aborto, mayor es la frecuencia de anomalías cromosómicas
detectadas. Cuanto mayor es la edad materna la frecuencia de
abortos espontáneos y las anomalías cromosómicas aumentan.
El diagnóstico prenatal plantea algunos
problemas éticos debido al hecho de que en algunos casos,
la existencia de enfermedades genéticas puede colocar a los
padres ante el dilema de tener que optar por la posibilidad
de abortar, o de sacar adelante un feto con alteraciones genéticas.
|
|